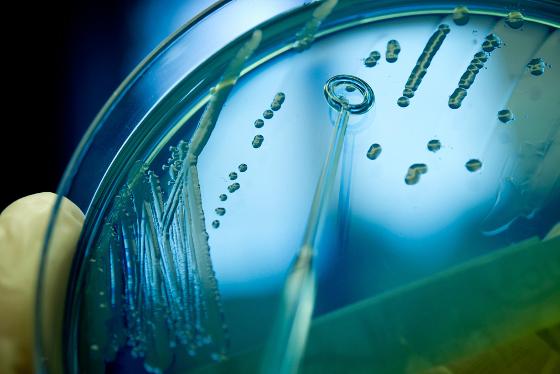
Petrisk&aring;l

Her får du en oversikt over hva vi har planlagt i vår. Vi håper å se deg på ett eller flere arrangementer!
Nyhetsarkiv
13.06.2025:
Nyhetsbrev høst 2025
05.12.2024:
Nyhetsbrev vår 2025

02.04.2024:
Nå er prosjektet VeiKomp Nord i gang
KickOff og planleggingsmøte for VeiKomp Nord ble gjennomført 21.mars på Linken møtesenter i Tromsø

14.03.2024:
Workshops 27. og 28.mai for undervisere som vil prøve virtuelle læringsressurser om terapeutisk kompetanse
Nå har du sjansen til å få prøve ut fire flotte virtuelle læringsresurser om terapeutisk kompetanse med tilhørende lærerveiledere som er utviklet av prosjektet TeraVRi. Det er begrenset med plasser - så meld deg på nå!

01.09.2023:
VeiKomp Nord - skal bidra til å å styrke helsepersonells veiledningskompetanse i nord!
VeiKomp Nord - Veiledningskompetanse for en bærekraftig helsetjeneste i Nord-Norge
Nå er vi i gang med prosjektet som skal gå over fem år fram til 2028!

23.08.2023:
Er du underviser og ønsker å teste ut virtuelle læringsressurser om terapeutisk kompetanse?
Er du underviser og ønsker å fornye din undervisningsform?

12.05.2023:
Kollegaveiledning som grunnlag for utvikling av undervisning og pedagogisk kompetanse.
Dette var tema på Helsefaglig pedagogisk webinar 27.04.23.
Innleder på webinaret var Monica Alterskjær Sundset, Professor ved Institutt for Arktisk og Marin Biologi ved UiT.

19.04.2023:
Invitasjon til den fjerde nasjonale forskningskonferansen i medisinsk og helsefaglig pedagogikk!
Kjære kollega,
Vedlagt finner du invitasjon til den fjerde nasjonale forskningskonferansen i medisinsk og helsefaglig pedagogikk.
21.02.2023:
HelPed arrangerer søkerseminar 6.mars kl.09.15-10.00
HK-dir utlyser midler med søknadsfrist 14.april 2023.

02.01.2023:
Mappevurdering-eksamensform og pedagogisk arbeidsmåte
Dette var tema på helsefaglig pedagogisk webinar 08.12.22. Innleder var Beate Ytreberg, førstelektor ved Bachelorutdanning i fysioterapi ved UiT.

17.11.2022:
Hvordan skrive gode flervalgsoppgaver og når er dette en god vurderingsform?
Dette var tema på helsefaglig pedagogisk webinar 27.10.22 med 32 deltakere på Teams. Katrine Wennevold, fagenhetsleder i allmennmedisin, har lang erfaring med temaet og innledet webinaret.

06.10.2022:
Visste du at du har tilgang til å bruke åpne digitale læringsressurser? Kom på Lunsj & Lær og bli inspirert!
Dette var tema på første Lunsj & Lær som samlet 25 fagansatte.
HelPed har startet en ny møtearena i høst som heter Lunsj & Lær!

05.09.2022:
Hvordan strukturere gruppeundervisning til det beste for studentenes læring?
Dette var tema på helsefaglig pedagogisk webinar 25.08. Innleder var Richard Fjellaksel, førsteamanuensis ved radiografutdanningen ved Helsefak

22.06.2022:
Studenter øver på teamkompetanse for å håndtere akutte situasjoner
Dette var tema på helsefaglig pedagogisk webinar 9.juni. Marianne Holmegård, universitetslektor og leder av Ferdighets- og simueringssenteret ved UNN/UiT innledet til diskusjon.

18.05.2022:
LOVU: En lærings- og vurderingsbank for felles læringsutbytter for helse- og sosialfagutdanningene. Et digitalt, tverrprofesjonelt og nasjonalt utdanningstilbud.
Dette var tema på helsefaglig pedagogisk webinar 12.mai.

02.05.2022:
OSCE (stasjonseksamen) i farmasiutdanningene
Innleder på webinaret var Kjell Halvorsen, førsteamanuensis og praksiskoordinator ved Institutt for farmasi.
24.03.2022:
Perspektiv på simuleringspedagogik – insikter från praktikbaserad forskning om simulering i hälso- och sjukvårdens utbildningar och praktik.
Dette var tema på helsefaglig pedagogisk webinar 17.mars.
Innleder var Madeleine Abrandt Dahlgren, professor i medisinsk pedagogikk ved Linkøping Universitet og professor II ved Helsefak/UiT.

14.03.2022:
Hvordan kan Digital Partner være en brobygger mellom fagmiljøene og andre enheter ved UiT?
Dette var tema på helsefaglig pedagogisk webinar 10.03.22 der 21 fagansatte deltok.

27.01.2022:
Ny digital læringsressurs om samenes rettigheter i helse- og sosialfagutdanningene
Årets første helsefaglige webinar ble innledet av Ann Ragnhild Broderstad, Senter for samisk helseforskning (SSHF) og overlege UNN og Iselin Caroline Finn, Rådgiver, Senter for samisk helseforskning (SSHF).

20.12.2021:
Lyst å vite mer om vårens webinarer?
Datoer for vårens helsefaglige pedagogiske webinarer finner sted torsdager hver måned: 27.01, 24.02, 17.03, 21.04, 19.05 og evt. 16.06. 22.
Sett av datoene allerede nå!

13.12.2021:
Dialogbaserte studentevalueringer av emner og program
Dette var tema på årets siste helsefaglige pedagogiske webinar 09.12.21.
Iris Borch, førsteamanuensis og leder av Senter for helsefaglig pedagogisk utvikling, innledet webinaret. Det var 34 påmeldte, og 24 deltok via Zoom. Studentevaluering er et tema som engasjerer mange, og dette var det andre webinaret i høst om dette temaet.

07.12.2021:
Meld deg på Veiledningskonferansen 09. og 10.februar 2022
Nå er programmet klart for Veiledningskonferansen 2022 som UiT Norges arktiske universitet arrangerer!
Påmeldingsfrist: 12. desember 2021.

03.11.2021:
Interaktiv video med H5P skaper nye studentaktive og tverrprofesjonelle læringsmuligheter
Nina B. Cheetham, førstelektor, Rita Jentoft, dosent og Rigmor Furu, førstelektor.
Studenter og lærere ved Bachelor i ergoterapi og desentralisert sykepleie (DSU) ved Institutt for helse- og omsorgsfag (IHO), har sammen med Senter for helsefaglig pedagogisk utvikling (HelPed) arbeidet med prosjektet Interaktiv video i læring (2019-2021). Prosjektet, som har utviklet digitale læringsressurser med studentaktive og interaktive læringsformer, er støttet av Program for undervisningskvalitet. Prosjektets formål har vært å lage læringsressurser som kan bidra til å styrke studentenes læring om tverrprofesjonell samhandling, øke deres digitale kompetanse og fremme kunnskap om velferdsteknologi.
Velferdsteknologi er en fellesbetegnelse på tekniske installasjoner og løsninger som kan (bedre) styrke den enkelte brukers evne og mulighet til å klare seg selv i egen bolig, og bidra til å sikre livskvalitet og verdighet (https://ehelse.no/velferdsteknologi). Målet med velferdsteknologi er å skape en enklere og tryggere hverdag både for brukere/pasienter, pårørende og omsorgspersonell.

03.11.2021:
Hacking og digital sikkerhet var tema på helsefaglig pedagogisk webinar
Er du redd for å bli hacket? Underviser du studenter tilknyttet RETHOS? Vil du vite mer om digital sikkerhet?
Innledere på webinaret: Anita Iversen, førsteamanuensis ved Senter for helsefaglig pedagogisk utvikling ved Helsefak og Johan Gustav Bellika, Professor ved UiT og forsker innen e-helse og analyse av helsedata ved Nasjonalt senter for e-helseforskning (NSE).

04.10.2021:
Inspirasjonswebinar: Innovasjon for økt arbeidsrelevans i helsefagutdanningene
Dette var tema på helsefaglig pedagogisk webinar 30.09. Det var 10 deltakere som fulgte webinaret på Zoom. Hva ligger i begrepet innovasjon, og hvorfor er det viktig for helsefagutdanningene?
Elin Astrid Gjøvik Glad, kommunikasjonsrådgiver i Faggruppe for kommunikasjon, formidling og studentrekruttering ved Seksjon for forskning, utdanning og formidling ved Helsefak, introduserte webinaret med å si noe om hva innovasjon kan være og delte eksempler fra Driv Hålogaland og Start UiT. "JA, Innovasjon er veldig relevant for helsefagutdanningene", sier Elin.

23.09.2021:
Skriftlige evalueringer og EvaluationKit, en introduksjon
Dette var tema på høstens første helsefaglige pedagogiske webinar 16. september. Det var 42 fagansatte som deltok på webinaret via Zoom. Webinaret hadde to innledere: Iris Borch, leder ved Senter for helsefaglig pedagogisk utvikling og Erlend Risvand Mo, førstekonsulent ved Seksjon for forskning og utdanningskvalitet, UiT.

24.08.2021:
Meld deg på webinar 7.september og hør om ny versjon av delingsplattformen DLR!
Ønsker du å vite mer om den nye versjonen av DLR, hvilke forbedringer som er gjort og hvordan din organisasjon kan ta DLR i bruk for å fremme deling og gjenbruk av læringsressurser?

18.06.2021:
Felles nasjonal delingsplattform i UH-sektoren og kultur for deling var tema for helsefaglig pedagogisk webinar
Nå får vi DLR i UH-sektoren, en felles nasjonal plattform for lagring, deling og gjenbruk av digitale læringsressurser. Hvordan kan du dele din undervisning? Christine Johnsen, rådgiver ved Direktoratet for fellestjenester i høyere utdanning og forskning, Unit og Svetlana P. Johansen, seniorrådgiver og jurist ved Seksjon for forskning og utdanningskvalitet ved UiT var innledere på webinaret med 19 deltakere (26 påmeldte).

01.01.2021:
Helsefaglig pedagogisk webinar (2021)
En oppsummering av Helsefaglig pedagogisk webinar som ble holdt i 2021.
01.01.2020:
Helsefaglig pedagogisk webinar (2020)
En oppsummering av Helsefaglig pedagogisk webinar som ble holdt i 2020.

01.01.2019:
Helsefaglig pedagogisk webinar (2019)
En oppsummering av Helsefaglig pedagogisk webinar som ble holdt i 2019.
01.01.2018:
Helsefaglig pedagogisk webinar (2018)
En oppsummering av Helsefaglig pedagogisk webinar som ble holdt i 2018.

01.01.2017:
Helsefaglig pedagogisk webinar (2017)
En oppsummering av Helsefaglig pedagogisk webinar som ble holdt i 2017.

14.01.2016:
Helsefaglig pedagogisk webinar (2016)
En oppsummering av Helsefaglig pedagogisk webinar som ble holdt i 2016.

29.01.2015:
Helsefaglig pedagogisk webinar (2015)
En oppsummering av Helsefaglig pedagogisk webinar som ble holdt i 2015.
11.09.2014:
Helsefaglig pedagogisk webinar (2014)
En oppsummering av Helsefaglig pedagogisk webinar som ble holdt i 2014.

02.04.2024:
Nå er prosjektet VeiKomp Nord i gang!
Kick/Off prosjekpplanlegging ble gjennomført 21.mars på Linken Møtesenter i Tromsø

19.12.2023:
Årets julebrev fra VeiKomp Nord
Les mer om hva som har skjedd i prosjektet VeiKomp Nord siden oppstarten i høst.

19.04.2023:
Invitasjon til den fjerde nasjonale forskningskonferansen i medisinsk og helsefaglig pedagogikk!
Kjære kollega,
Vedlagt finner du invitasjon til den fjerde nasjonale forskningskonferansen i medisinsk og helsefaglig pedagogikk.
24.03.2022:
Perspektiv på simuleringspedagogik – insikter från praktikbaserad forskning om simulering i hälso- och sjukvårdens utbildningar och praktik.
Dette var tema på helsefaglig pedagogisk webinar 17. mars:
Innleder var Madeleine Abrandt Dahlgren, professor i medisinsk pedagogikk ved Linkøping Universitet og professor II ved Helsefak/UiT.
14.03.2022:
Hvordan kan Digital Partner være en brobygger mellom fagmiljøene og andre enheter ved UiT?
Dette var team på helsefaglig pedagogisk webinar 10.03.22
























.jpg)









.jpg)




























